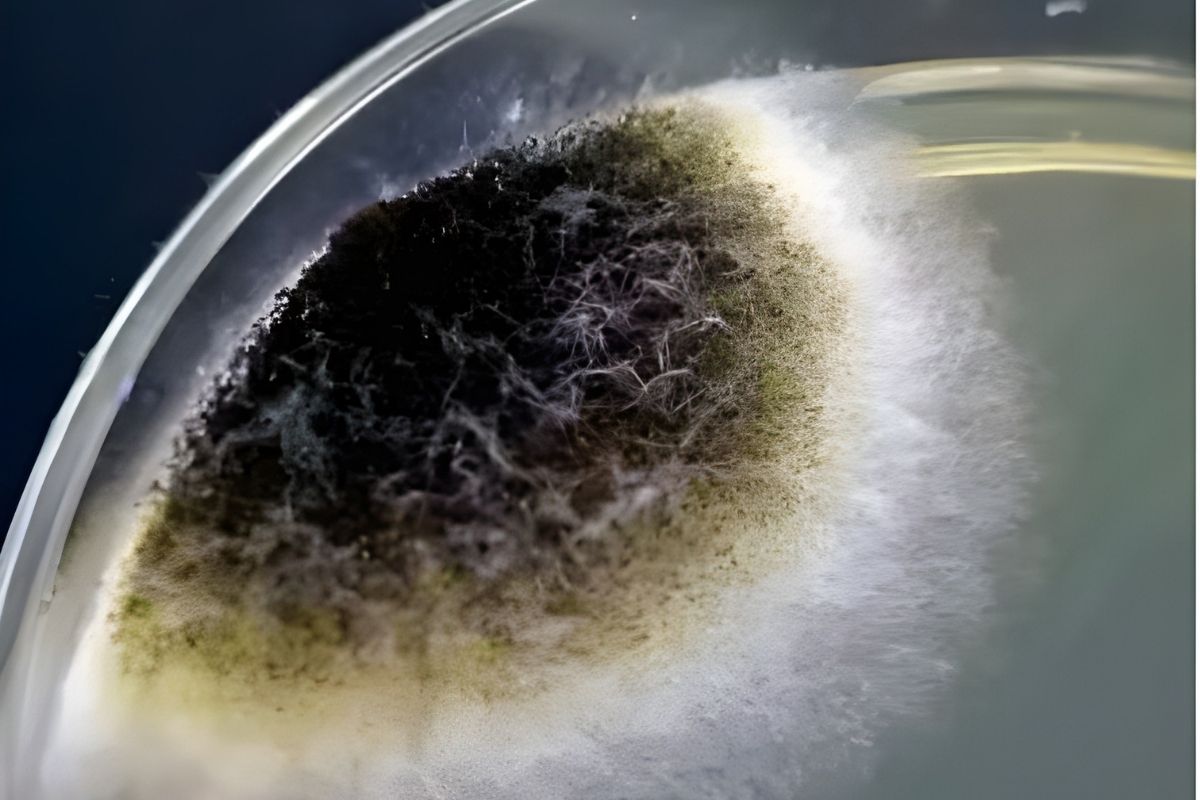
Understanding Citric Acid: Uses, Production, and Health Impacts

Which Foods Are Causing Inflammation in Your Body?
If you live in the modern world, it's very likely that you'll have inflammation in your body — and your diet may be the biggest driver.
Root cause healthcare. Evidence-informed writing. Real answers for how your body actually works.
If you live in the modern world, it's very likely that you'll have inflammation in your body — and your diet may be the biggest driver.

Alcohol is not just a mind-altering substance — it is also a poison that disrupts your metabolism, brain chemistry, and immune health, even at low to moderate levels.

Not all protein bars are created equal — some support steady energy and metabolic health, while others are loaded with sugar and processed ingredients that can set you back.

Most people enter ketosis for weight loss and energy. For some, ketones become something more — a signaling molecule that heals the brain, calms the gut, and restores immune balance
That ingredient listed on nearly every packaged food? It's not from lemons. And for some people, the difference matters more than they realize.

Protein powder is in every smoothie and morning routine — but under the glossy packaging, many of these products carry stories most people never hear.